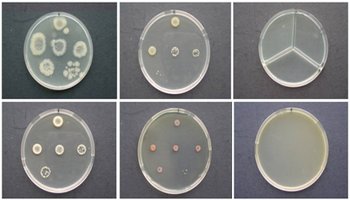
PSL%202014 vol07-no02-p356-371%20Robidillo

VOLUME 7 NUMBER 2 (July to December 2014)
Philipp. Sci. Lett. 2014 7 (2) 356-371
available online: November 11, 2014
*Corresponding author
Email Address: ctrobidillo@up.edu.ph
Received: July 17, 2014
Revised: September 17, 2014
Accepted: September 22, 2014
ARTICLE
Biosorption of copper (II) by live biomasses of two indigenous bacteria isolated from copper contaminated water
by Christopher Jay T. Robidillo1*, Nelson R. Villarante1, and Lorele C. Trinidad2
1Department of Physical Sciences and Mathematics, College of Arts and Sciences, University of the Philippines Manila
2National Institute of Molecular Biology and Biotechnology, University of the Philippines Los Baños
2National Institute of Molecular Biology and Biotechnology, University of the Philippines Los Baños
The study investigated the potential of intrinsic bioremediation of copper using indigenous resistant bacterial flora. Screening and isolation of bacteria were carried out from copper-contaminated water samples of Bol River Reservoir, Marinduque, Philippines. Bacterial colonies grew on amended nutrient agar plates containing 50, 100, and 200 ppm copper. Four copper-resistant bacteria were isolated and purified. The biomasses of the least and most resistant isolates, namely Staphylococcus sciuri and Bacillus fastidiosus, were used as adsorbents for the removal of copper from aqueous solutions. Removal efficiencies depended on pH and biomass dosage, leveled off with time, and decreased with initial copper concentration. The biosorption of copper on both biomasses correlated well with the Langmuir isotherm (r2 = 0.95 and 0.99). In keeping with its greater resistance, the Langmuir model revealed that B. fastidiosus has approximately 27% more adsorption sites on its surface than S. sciuri. However, B. fastidiosus has weaker affinity for copper than S. sciuri. The maximum adsorption capacities obtained for B. fastidiosus and S. sciuri compare well with those of other microbes reported in the literature. The Scatchard plots indicated that both bacterial surfaces contain multiple binding sites and that the adsorption of copper exhibits negative cooperative behavior. Also, the biomasses removed copper from actual wastewater with up to 90% efficiency, with negative deviations from expected removal efficiencies attributable to the presence of iron and zinc. Unfortunately, the actual use of S. sciuri in bioremediation is precluded by its pathogenicity. The same, however, is not true with B. fastidiosus. Thus, B. fastidiosus can potentially be used as an efficient and non-pathologic bioremediating agent for copper.
© 2026 SciEnggJ
Philippine-American Academy of Science and Engineering